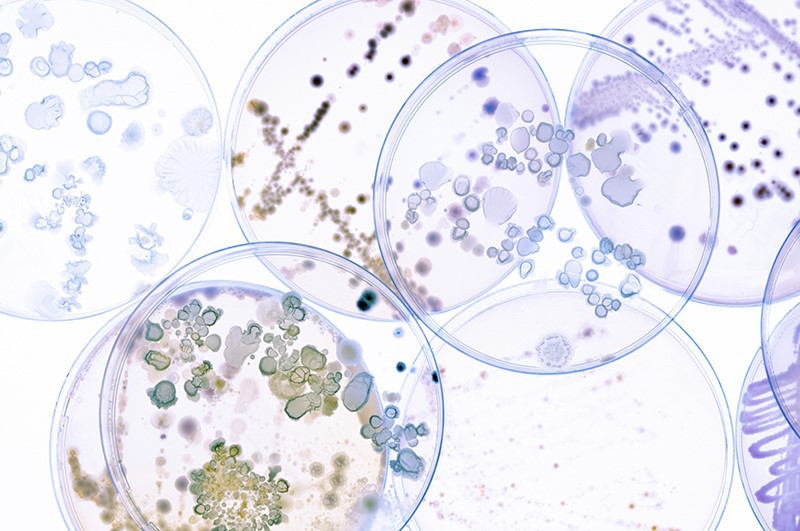
Differences between Bifidobacterium longum and Bifidobacterium breve Differences between Bifidobacterium longum and Bifidobacterium breve

Основната разлика междуBifidobacterium longumиBifidobacterium breveе, че те имат различни ефекти и приложения .
1. различни ефекти
Bifidobacterium longum is usually a substance contained in the intestinal flora, which can inhibit the appearance of harmful bacteria in the intestines, and can also speed up the peristalsis of the gastrointestinal tract, which can effectively adjust the gastrointestinal tract. However, with the continuous increase of age, the number of Bifidobacterium longum in the intestines will gradually Намаляване . Някои възрастни пациенти са склонни към симптоми на запек, което може да бъде причинено от постепенното намаляване на бифидобактерията longum в червата . bifidobacterium breve може ефективно да подобри феномена на натрупване на мазнини в тялото мазнини .
2. различни приложения
Като цяло, bifidobacterium longum често се използва в терапевтични лекарства . bifidobacterium auris се използва широко в здравословни храни, напитки и млечни киселини .
Когато има дисбаланс в чревната флора, това може да причини диария ., се препоръчва да приемате лекарства, съдържащи бифидобактерия longum за лечение своевременно според съвета на лекаря .





